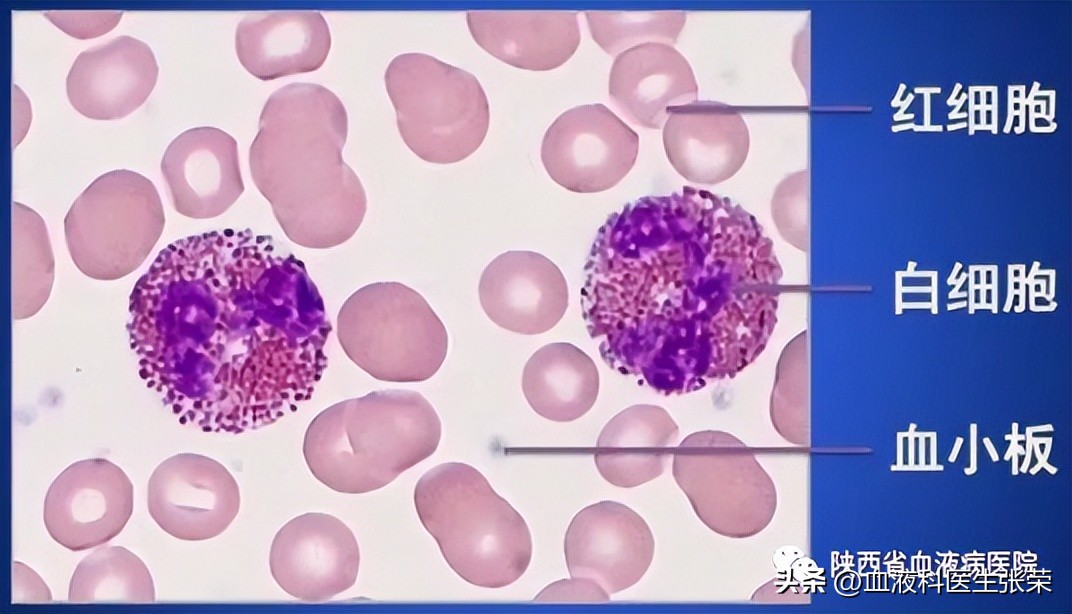
MDS“康复难”不仅是骨髓造血的问题，还有这三种原因

骨髓增生异常综合征是起源于造血干细胞的一组异质性髓系克隆性疾病,特点是髓系细胞分化及发育异常,自身不能正常造血,表现为无效造血、难治性血细胞减少、造血功能衰竭,高风险向急性白血病转化,这是人们对于MDS的普遍认知,但其实,除了疾病本身的原因还有这三个治疗难点,下面跟随陕西省血液病研究所附属医院一起来看看吧!

难点一:MDS的诊断
MDS诊断的可靠性。鉴别诊断,MDS排除诊断应包括有关溶血性贫血、再生障碍性贫血、恶性肿瘤、肝病、肾病、免疫系统疾病及结核病的检查。
难点二:自行减停药物,病情无法达到持续“完全缓解”
患者缓解与否,判断标准如下:
1、骨髓: 原始细胞≤5%且所有细胞系成熟正常;
2、外周血: 血红蛋白: ≥110g/L ,中性粒细胞:≥1.0×10^9/L ,血小板:≥100×10^9/L ,原始细胞0%。
3、部分缓解: 外周血绝对值必须持续至少2个月 ,其它条件均达到完全缓解标准,骨髓原始细胞较治疗前减少≥50%,但仍>5%。
判断MDS是否治疗缓解,其参考信息还包括骨髓完全缓解,血液学改善,红系反应等等。而大多数患者对于MDS的疗效的判断标准并不清楚,觉得血常规恢复差不多,骨髓原始细胞明显下降了,自己的病就好的差不多了,因此停止治疗减停药物,病情反复。
难点三:对MDS缺乏有效的治疗方法
目前针对不同类型的MDS,采用相应的不同治疗对策。结合本病病机及临床经验,采用中医辨证论治的原则,在临床实践中按MDS危险分级,疾病各期各阶段杂证变证的特点,正邪消长的趋势,将辨证辨病相结合,采用益气养阴扶正的治疗方法,且清热解毒、活血化瘀不同程度地贯彻在辩证治疗的始终。

1、在低危期患者治疗中常可大胆使用温肾填精益髓的血肉有情之品;
2、中危期患者诊治过程中,解毒复髓当为重中之重,同时兼顾扶正、健脾、益肾、活血、化瘀,辨证施治;
3、高危期患者,采用扶正抗癌,增强免疫,抑制肿瘤的中药诱导等方法,对患者改善症状,克服骨髓抑制,减少化疗药物对胃肠道及肝肾功能的影响。